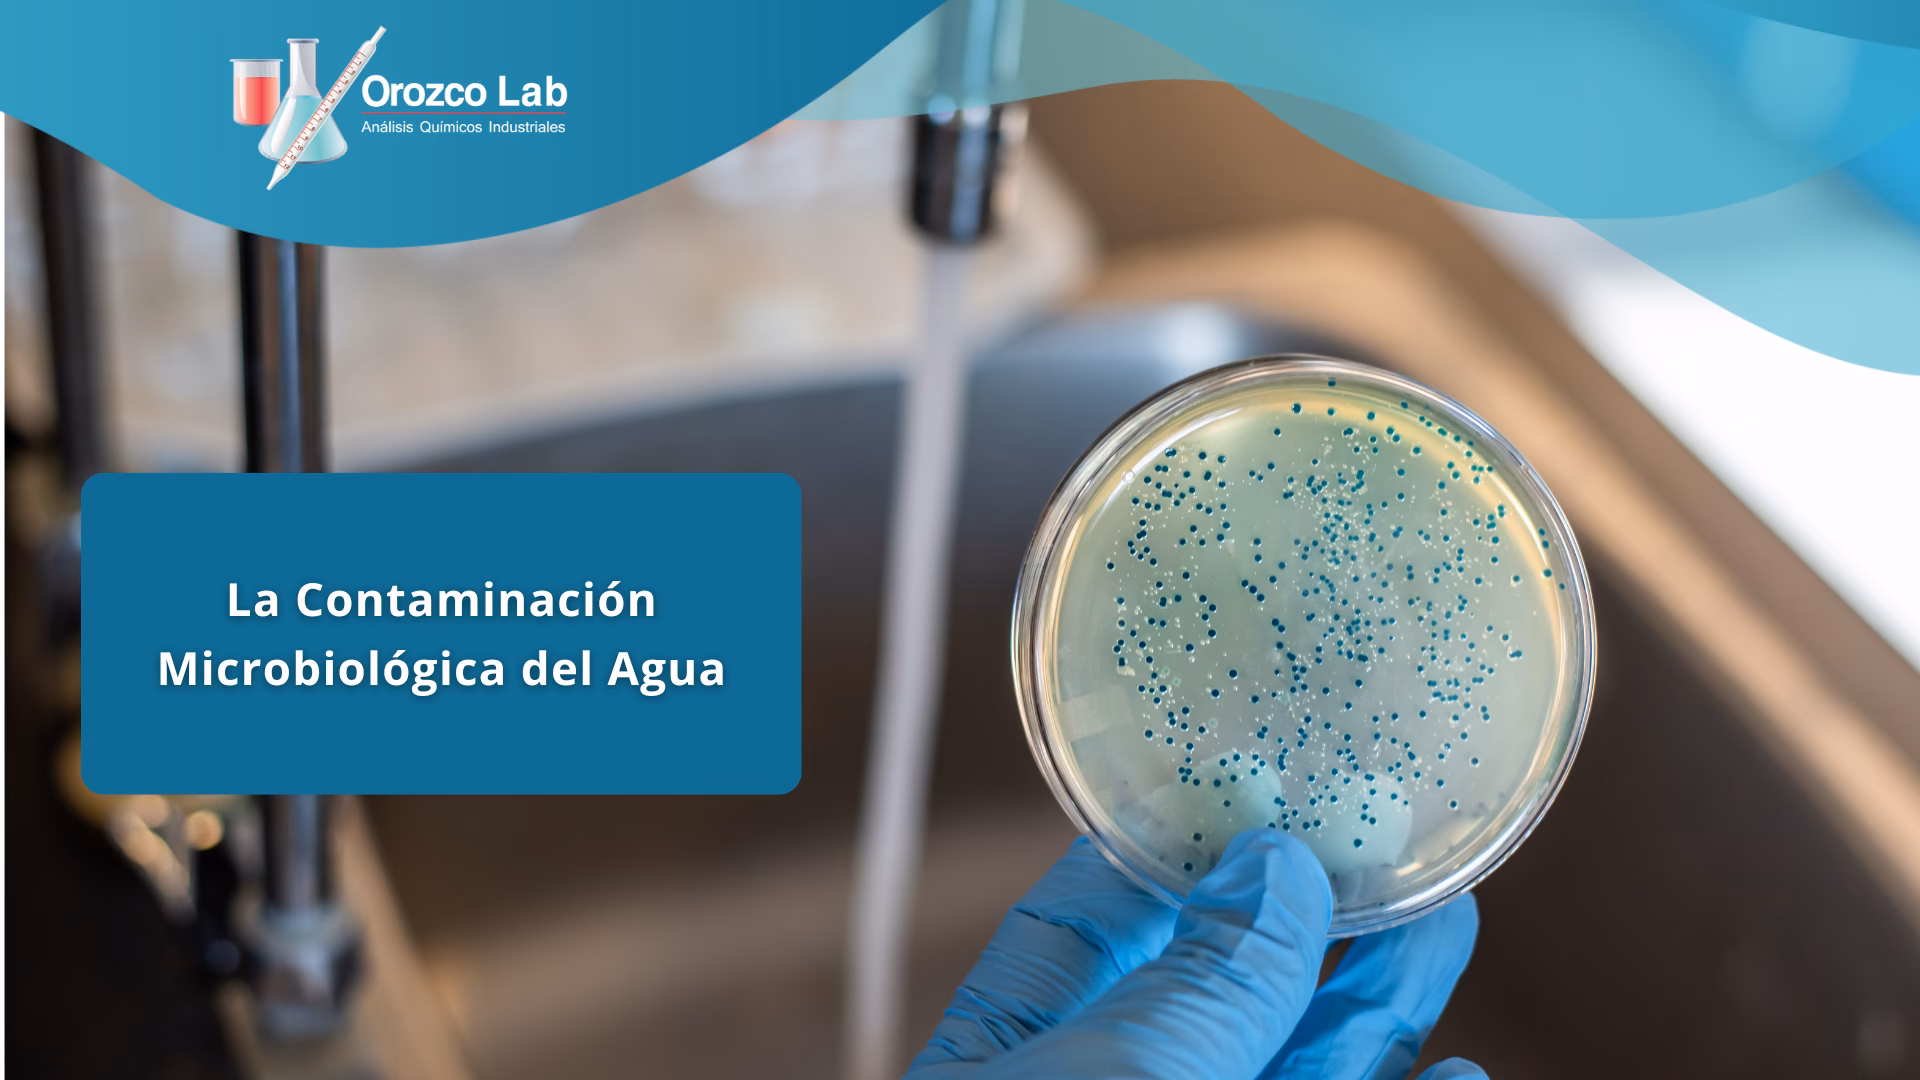
¿Cuáles son las causas de la contaminación del agua?

19/07/2005
El agua es el pilar fundamental de la vida en nuestro planeta. Cada ser vivo, desde la planta más pequeña hasta el ser humano, depende de ella para sobrevivir. Es un recurso que a menudo damos por sentado, abriendo el grifo sin pensar en el complejo viaje que ha realizado para llegar hasta nosotros. Sin embargo, esta fuente de vida se encuentra bajo una amenaza constante y creciente. La actividad industrial, las malas prácticas agrícolas y la gestión inadecuada de residuos están degradando la calidad de nuestras fuentes de agua, introduciendo en ella un cóctel de contaminantes químicos y biológicos que ponen en jaque nuestra salud y la de los ecosistemas.

Si bien la imagen de una tubería vertiendo desechos de colores en un río es la estampa clásica de la contaminación, existe un peligro mucho más sutil e invisible: la contaminación biológica. Se trata de un enemigo silencioso, compuesto por un ejército de microorganismos que, una vez que ingresan en nuestro cuerpo, pueden causar estragos. Comprender qué son, de dónde vienen y cómo nos afectan es el primer paso para protegernos de esta amenaza latente.
Fuentes Principales de la Contaminación Hídrica
La contaminación del agua no proviene de una única fuente, sino de una combinación de factores que actúan de forma sinérgica, deteriorando su calidad. Podemos clasificar estas fuentes en dos grandes grupos: la contaminación química y la biológica.
La Amenaza Química: Residuos Industriales y Agrícolas
Las fábricas y naves industriales son uno de los focos más conocidos de contaminación. A menudo, vierten directamente en ríos y lagos una variedad de sustancias tóxicas, como metales pesados (mercurio, plomo, cadmio), disolventes y otros compuestos químicos derivados de sus procesos de producción. Estos contaminantes no solo envenenan la vida acuática, sino que pueden filtrarse en las aguas subterráneas, contaminando los acuíferos que abastecen de agua potable a las poblaciones. De manera similar, la agricultura intensiva utiliza grandes cantidades de pesticidas y fertilizantes que, arrastrados por la lluvia, terminan en las vías fluviales, provocando la eutrofización (crecimiento excesivo de algas que agota el oxígeno del agua) y contaminando el recurso con nitratos y otros químicos.
El Enemigo Invisible: La Contaminación Biológica
Esta forma de contaminación es causada por la presencia de organismos vivos microscópicos, principalmente virus, bacterias, protozoos y hongos. Estos agentes patógenos llegan al agua a través de diversas vías, como el vertido de aguas residuales sin tratar, la escorrentía de granjas con desechos animales o la contaminación cruzada en sistemas de distribución de agua deficientes. Una vez en el agua, estos microorganismos pueden proliferar, convirtiendo una fuente de vida en un vehículo de enfermedades.
Conociendo a los Microorganismos Patógenos del Agua
Para entender el riesgo real, es crucial diferenciar los tipos de agentes biológicos que podemos encontrar en el agua contaminada.
Virus: Los Invasores Celulares
Los virus son los agentes infecciosos más pequeños. No son células completas, sino material genético encapsulado que necesita invadir una célula viva (humana, animal o bacteriana) para poder replicarse. Son parásitos intracelulares obligados. En el agua, pueden sobrevivir durante periodos variables, esperando a un huésped. Algunos de los virus transmitidos por el agua más comunes incluyen el virus de la Hepatitis A, el Norovirus (causa común de gastroenteritis aguda) y el Rotavirus.
Bacterias: Organismos Complejos y Resistentes
Las bacterias son organismos unicelulares más complejos que los virus. A diferencia de ellos, no necesitan invadir otra célula para reproducirse; pueden hacerlo por sí mismas si las condiciones son adecuadas. Algunas bacterias son increíblemente resistentes. Tienen la capacidad de formar esporas, una especie de estado latente que les permite sobrevivir en condiciones extremas de sequía, calor o falta de nutrientes. Cuando las condiciones vuelven a ser favorables, la espora germina y la bacteria recupera su actividad. Ejemplos peligrosos en el agua incluyen la Escherichia coli (E. coli), Salmonella (causante de la salmonelosis), Vibrio cholerae (agente del cólera) y la Legionella. Esta última es particularmente notoria por su capacidad para sobrevivir y multiplicarse en sistemas de agua artificiales, como torres de refrigeración de aire acondicionado o calentadores de agua, pudiendo transmitirse por la inhalación de aerosoles contaminados.
Hongos y Protozoos: Los Oportunistas
Aunque a menudo se asocian con alimentos en mal estado o problemas de humedad en el hogar, ciertos hongos y mohos también pueden contaminar el agua. Si se ingieren, algunas especies pueden producir micotoxinas perjudiciales para la salud. Por otro lado, los protozoos son organismos unicelulares más grandes que las bacterias, como Giardia lamblia y Cryptosporidium, que causan graves enfermedades gastrointestinales y son muy resistentes a los desinfectantes comunes como el cloro.
Tabla Comparativa de Microorganismos Acuáticos
| Microorganismo | Características Principales | Ejemplos Comunes | Enfermedades Asociadas |
|---|---|---|---|
| Virus | Parásitos intracelulares, muy pequeños, necesitan un huésped para replicarse. | Hepatitis A, Norovirus, Rotavirus. | Hepatitis, gastroenteritis viral. |
| Bacterias | Organismos unicelulares, se reproducen por sí mismas, algunas forman esporas resistentes. | E. coli, Salmonella, Legionella, Vibrio cholerae. | Cólera, fiebre tifoidea, legionelosis, gastroenteritis bacteriana. |
| Protozoos | Unicelulares más grandes que las bacterias, forman quistes resistentes. | Giardia lamblia, Cryptosporidium. | Giardiasis, criptosporidiosis (diarreas severas). |
| Hongos | Pueden ser unicelulares o pluricelulares, algunos producen toxinas. | Aspergillus, Fusarium (mohos). | Infecciones oportunistas, problemas por micotoxinas. |
Consecuencias para la Salud: Enfermedades de Transmisión Hídrica
El consumo de agua contaminada, ya sea directamente o al utilizarla para preparar alimentos, es una de las principales causas de enfermedad a nivel mundial. El peligro es especialmente grave en comunidades con infraestructuras de saneamiento deficientes o sin acceso a fuentes de agua seguras. Las enfermedades más comunes se pueden agrupar en varias categorías:
- Gastrointestinales: Son las más frecuentes. Cursan con síntomas como diarrea, vómitos, calambres abdominales y deshidratación. El cólera, la fiebre tifoidea y las infecciones por E. coli son ejemplos graves.
- Cutáneas y Oculares: El contacto con agua contaminada durante el baño o actividades recreativas puede provocar infecciones en la piel como la tiña, sarna o dermatitis, así como infecciones oculares como la conjuntivitis.
- Sistémicas: Algunas enfermedades, como la hepatitis A, afectan a órganos específicos como el hígado, mientras que otras como la leptospirosis pueden afectar a todo el organismo.
¿Cómo Podemos Eliminar los Patógenos del Agua en Casa?
La detección de patógenos específicos en el agua es un proceso complejo que requiere análisis de laboratorio. Por ello, la prevención y la purificación son nuestras mejores herramientas a nivel doméstico. Si tienes dudas sobre la calidad del agua de tu grifo, existen varios métodos para hacerla más segura.
Uno de los métodos más antiguos y efectivos es hervir el agua. Llevar el agua a un punto de ebullición vigoroso durante al menos un minuto (tres minutos en altitudes elevadas) es suficiente para matar la mayoría de virus, bacterias y protozoos.
La cloración es otro método común, utilizado a gran escala en las plantas de tratamiento. A nivel doméstico, se puede usar lejía sin perfume en dosis muy pequeñas, pero es un proceso delicado. Como se mencionó, el cloro es un químico potente y una dosificación incorrecta puede ser perjudicial para la salud. Por ello, si se opta por este método, es fundamental seguir las indicaciones de expertos o de las autoridades sanitarias locales.
Finalmente, existen sistemas de filtración y purificación doméstica. Desde jarras con filtros de carbón activado, que mejoran principalmente el sabor y olor, hasta sistemas más avanzados de ósmosis inversa o luz ultravioleta (UV) que son capaces de eliminar o inactivar un amplio espectro de contaminantes, incluidos los microorganismos. La elección del sistema dependerá de la calidad del agua de origen y de los contaminantes específicos que se deseen eliminar.
Preguntas Frecuentes (FAQ)
¿Si el agua se ve clara y no huele mal, es segura para beber?
No necesariamente. Los contaminantes biológicos como virus y bacterias son microscópicos e invisibles al ojo humano. Un agua cristalina y sin olor puede albergar una gran cantidad de patógenos peligrosos. Nunca se debe juzgar la seguridad del agua únicamente por su apariencia.
¿Es seguro beber directamente de un manantial o río en la montaña?
Aunque parezca pura, el agua de fuentes naturales puede estar contaminada por los excrementos de animales salvajes, que pueden ser portadores de bacterias como E. coli o protozoos como Giardia. Siempre es más seguro tratar o purificar el agua antes de consumirla, incluso en entornos aparentemente prístinos.
¿Los filtros de jarra comunes eliminan los virus y las bacterias?
La mayoría de los filtros de jarra estándar están diseñados para reducir el cloro, el plomo y otros contaminantes que afectan el sabor y el olor. Generalmente, no son eficaces para eliminar microorganismos como virus y bacterias. Para ello, se necesitan filtros específicos con poros mucho más pequeños (microfiltración, ultrafiltración) o sistemas de purificación por UV u ósmosis inversa.
¿Por qué la Legionella es tan particular?
La Legionella es una bacteria que prospera en agua estancada a temperaturas templadas (entre 20°C y 45°C), condiciones que se dan en muchos sistemas de agua caliente, spas o torres de refrigeración. Su principal peligro no es la ingestión, sino la inhalación de pequeñas gotas de agua (aerosoles) contaminadas, lo que puede causar una forma grave de neumonía conocida como legionelosis.
En conclusión, la protección de nuestras fuentes de agua es una responsabilidad compartida. Desde exigir políticas de control de vertidos más estrictas a las industrias hasta adoptar prácticas de consumo responsable en nuestros hogares, cada acción cuenta. Asegurar la calidad del agua que bebemos no es solo una cuestión de comodidad, sino un pilar fundamental de la salud pública y la preservación de la vida en nuestro planeta.
Si quieres conocer otros artículos parecidos a Contaminación del Agua: Causas y Riesgos Ocultos puedes visitar la categoría Ecología.